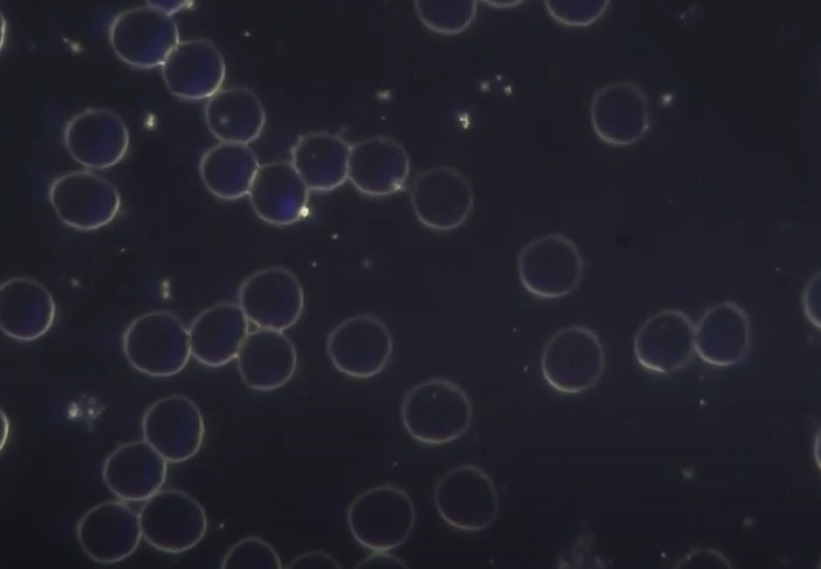

Agua de GRANDER® y la sangre humana
Se han realizado muchos estudios sobre las características de la sangre en personas pero destacamos el realizado por un nutricionista especializado en microscopia nutricional, y supervisado por médicos, donde explica con claridad los efectos positivos de la toma del agua de Grander, comprobados en la microscopía de campo oscuro.
Experimentación sobre una muestra de individuos:
Se extrae una gota de sangre a estos individuos, guardándose y analizándose; sin alterar sus hábitos cotidianos mas que con la bebida diaria de 200ml revitalizada GRANDER®, y se vuelve a analizar con una nueva extracción pasados 20 días.

Interpretación de una muestra inicial
Se observa en la imágen un gran nivel de apilamiento de los glóbulos en general, lo que significa que esta persona sufre de una hipoxia celular o lo que es lo mismo, no llega oxígeno a los tejidos de forma normal, los glóbulos rojos carecen de movilidad y esto provoca un nivel de inflamación a articulaciones y sensación de fatiga que con el tiempo podría generar un problema metabólico u otra patología.

Interpretación de la misma muestra pasados los 20 días
Las membranas de los globulos rojos tienen ahora su propio espacio y no se ven en contacto ni entremezcladas, los niveles de oxígeno se están regulando, quedan bien marcadas las áreas de los mismos y sin obstaculizarse, los niveles de coagulación han bajado; si no tienen movilidad, es a causa de estar tiempo sin mobilidad por la hipoxia de origen, no hay aplilamiento, con esta disposición se pueden eliminar mejor las toxinas, y esto conlleva un equilibrio del PH de la sangre.
Evaluación personal
La persona manifiesta que ha sentido más actividad, ha dormido mejor y se siente con más energía vital, sensaciones similares a haber efectuado un detox (es el procedimiento de desintoxicación o limpieza del organismo) bebiendo agua de GRANDER, este procedimiento no es invasivo ni se ayuda de fármacos por lo que las ventajas a nivel de salud son óptimas sin efectos secundarios.